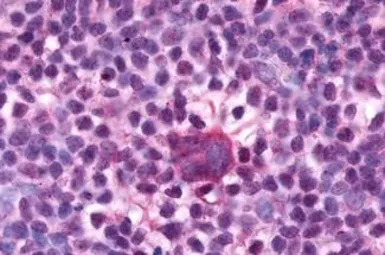
F4/80 antibody

相关产品推荐更多 >
万千商家帮你免费找货
0 人在求购买到急需产品
- 详细信息
- 文献和实验
- 技术资料
- 免疫原:
Synthetic 16 amino acid peptide from N-terminal extracellular domain of human EMR1.
- 亚型:
IgG
- 形态:
Liquid
- 保存条件:
Store as concentrated solution. Centrifuge briefly prior to opening vial. For short-term storage (1-2 weeks), store at 4ºC. For long-term storage, aliquot and store at -20ºC or below. Avoid multiple freeze-thaw cycles.
- 克隆性:
Polyclonal
- 标记物:
Unconjugated
- 适应物种:
Human
- 保质期:
12 months from the shipping date of the product.
- 抗原来源:
Human
- 目录编号:
GTX77949
- 级别:
Primary Antibodies
- 库存:
Available
- 供应商:
GeneTex
- 宿主:
Rabbit
- 应用范围:
IHC-P
- 浓度:
1 mg/ml (Please refer to the vial label for the specific concentration.)
- 靶点:
F4/80
- 抗体英文名:
F4/80 antibody
- 抗体名:
F4/80 抗体
- 规格:
25 μg

IHC-P analysis of human bone marrow tissue using GTX77949 F4/80 antibody.
Antigen retrieval : Heat-induced antigen retrieval

IHC-P analysis of human lung, adenocarcinoma tissue using GTX77949 F4/80 antibody.
Antigen retrieval : Heat-induced antigen retrieval
IHC-P analysis of human lymph node, hodgkins lymphoma tissue using GTX77949 F4/80 antibody.
Antigen retrieval : Heat-induced antigen retrieval
风险提示:丁香通仅作为第三方平台,为商家信息发布提供平台空间。用户咨询产品时请注意保护个人信息及财产安全,合理判断,谨慎选购商品,商家和用户对交易行为负责。对于医疗器械类产品,请先查证核实企业经营资质和医疗器械产品注册证情况。
 文献和实验
文献和实验8.0) in clean 16x125mm polypropylene test tube. If needed, adjust pH to 8.0 using 0.5M carbonate buffer. 2. Prepare fresh, 1mg/mL of either NHS-FITC in DMSO or 1mg/mL NHS-LC-Biotin in DH2O. If FITC coupling, add 75uL of FITC/DMSO solution to Antibody
8.0) in clean 16x125mm polypropylene test tube. If needed, adjust pH to 8.0 using 0.5M carbonate buffer. 2. Prepare fresh, 1mg/mL of either NHS-FITC in DMSO or 1mg/mL NHS-LC-Biotin in DH2O. If FITC coupling, add 75uL of FITC/DMSO solution to Antibody
Generation of Antibody Molecules Through Antibody Engineering
been overcome to a large extent using genetic-engineering techniques to produce chimeric mouse/human and completely human antibodies. Such an approach is particularly suitable because of the domain structure of the antibody molecule ( 2 ), where functional
 技术资料
技术资料暂无技术资料 索取技术资料





![RFC4 antibody [N1C3]](https://img1.dxycdn.com/2023/0711/255/2344116916935858761-14.jpg!wh200)
![RAB8A antibody [ARC2968]](https://img1.dxycdn.com/2023/0711/451/6106825198874858761-14.jpg!wh200)


